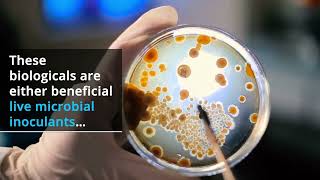

Biologicals and Biostimulants, Crops & Soils video
Online izle ve mp4 mp3 formatlarinda yukle
Videonun muddeti: 1:56
Biologicals and Biostimulants, Crops & Soils videosu mp4 ve mp3 yuklemek ucun hazirdir
Diqqet! Siz Mp4 yukle ve ya Mp3 yukle duymesine basdiqdan sonra eger sistem sizi reklam sehifesine atarsa o zaman derhal geri qayidib emeliyyati tekrar edin ve faylin yuklemek ucun hazir olmasini gozleyin
Videodan Mp4 Yukle
Videodan Mp3 Yukle-1
Videodan Mp3 Yukle-2
Oxshar Axtarishlar
Biologicals and Biostimulants, Crops & Soils
How do biostimulants work?
Understanding Biologicals: How to Enhance Soil Health & Crop Nutrition | Farmer2FarmerVI
What are Biostimulants
Biologicals and Biostimulants: The Effect on Nutrient Management [Product Demo]
NPK-University Organic Biostimulants With Harley Smith
Biologicals as Fertilizers in Organics
Understanding Biologicals for Sustainable Agriculture
Fertilisers, soil conditioners, biological inoculants and biostimulants
Video Mp4 Mp3Azwap.Biz
Azwap.Biz 2021-2023